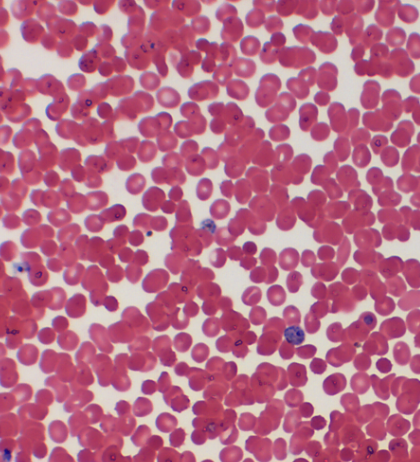
knowt flashcard image

BIOL 202 Bacteria and Protists
0.0(0)
Card Sorting
1/16
Earn XP
Description and Tags
Specimen photos for lab 2 + 3
Last updated 7:14 PM on 12/1/25
Name | Mastery | Learn | Test | Matching | Spaced | Call with Kai |
|---|
No analytics yet
Send a link to your students to track their progress
17 Terms
1
New cards
Spirochaetes

2
New cards
Actinobacteria

3
New cards
Cyanobacteria

4
New cards
Proteobacteria

5
New cards
Euglenoids

6
New cards
Kinetoplastids

7
New cards
Chlorophyta

8
New cards
Rhodophyta

9
New cards
Ciliophora

10
New cards
Apicomplexa
11
New cards
Dinozoa

12
New cards
Bacillariophyceae

13
New cards
Phaeophyceae

14
New cards
Radiolaria

15
New cards
Foraminifera

16
New cards
naked amoebas

17
New cards
Choanoflagellates
